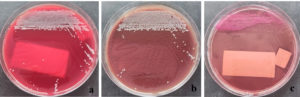

ISSN: 0973-7510
E-ISSN: 2581-690X
Acinetobacter baumannii is a Gram-negative bacterium frequently found in intensive care patients, patients with burns, and those with skin infections and pneumonia. These bacteria can cause necrotizing pneumonia and trigger inflammation, making the lung tissue more susceptible to pneumothorax. Here, we present the case of a male patient who experienced two episodes of secondary spontaneous pneumothorax due to A. baumannii infection. This case highlights the role of A. baumannii infection in patients with secondary spontaneous pneumothorax and the importance of appropriate management to prevent further complications.
Acinetobacter baumannii, Secondary Spontaneous Pneumothorax, Pneumonia, Bronchoalveolar lavage
Acinetobacter baumannii is a Gram-negative bacterium frequently isolated in microbiology laboratories, particularly from intensive care patients, patients with burns, and those with skin infections and pneumonia. A. baumannii has been reported as one of the causes of necrotizing pneumonia,1 alongside other common pathogens such as Streptococcus pneumoniae, Staphylococcus aureus, Klebsiella pneumoniae, Haemophilus influenzae, and Pseudomonas aeruginosa.2 The inflammation and infection caused by these microorganisms weaken the lung tissue near the pleura, increasing its susceptibility to air leakage into the pleural cavity. The presence of air in the pleural cavity, known as pneumothorax, which occurs spontaneously (not due to trauma), can be classified as primary spontaneous pneumothorax (PSP), which occurs without any pre-existing lung disease, or secondary spontaneous pneumothorax (SSP), which is associated with underlying lung conditions such as infection, chronic obstructive pulmonary disease (COPD), or pulmonary fibrosis. Here, we report a case of A. baumannii isolated from a male patient who experienced secondary spontaneous pneumothorax twice. A deeper understanding of the relationship between A. baumannii infections and spontaneous pneumothorax is expected to enhance clinical awareness and optimize the management of high-risk patients.
Case presentation
A 69-year-old male patient presented to the emergency department of Dr. Soetomo General Hospital with complaints of cough and shortness of breath that had started 30 min earlier. At the time of admission, the patient was alert and febrile with a temperature of 37.9 °C. His blood pressure was 129/70 mmHg, heart rate was 120 beats/min, and respiratory rate 28 times/min. Oxygen saturation reached 98% while receiving oxygen through a non-rebreathing mask at a flow rate of 10 L/min; history revealed that the patient had experienced similar symptoms two weeks prior and was diagnosed with spontaneous pneumothorax. The patient was then suspected of having pulmonary tuberculosis, especially considering that tuberculosis is endemic to Indonesia. The patient immediately underwent needle thoracentesis, followed by a GeneXpert® MTB/RIF Ultra test on a sputum specimen, which yielded negative results. The patient also underwent chest tube placement with active suction during the previous hospitalization period. After several days with a chest tube in place, the patient underwent a bullectomy and wedge resection using Video-Assisted Thoracoscopic Surgery (VATS). Upon showing improvement, the patient was discharged in a stable condition, with no shortness of breath, occasional coughing, good oral intake, and oxygen saturation levels of 96-98% on room air. However, the patient returned to the emergency room one day after discharge with the same complaints, namely sudden onset of cough and shortness of breath. Asymmetrical chest wall movement was noted, with the right-side lagging, accompanied by diminished vesicular breath sounds on the right side. Chest radiography revealed signs of pneumonia and right-sided pneumothorax (Figure 1).
The patient was diagnosed with a second attack of secondary spontaneous pneumothorax and underwent the placement of an indwelling pleural catheter along with oxygen support via a non-rebreathing mask at 14 L/min. Two days later, a bronchoscopy revealed a narrowed lumen in the right middle lobe, likely due to external compression from the air inside the pleural cavity. Bronchoalveolar lavage (BAL) specimens were collected from the right and left sides for microbiological examination. The BAL specimen was then tested using the GeneXpert® MTB/RIF Ultra assay, and the result was negative. Gram staining of the right BAL specimen showed polymorphonuclear cells (3+), indicating an inflammatory process. No bacterial forms were observed in either specimen. The samples were then cultured on blood agar, MacConkey agar, and chocolate agar before incubation. After 24 h of incubation, small, round, convex gram-negative rod-shaped colonies were observed in both the right BAL (Figure 2) and left BAL (Figure 3) specimens. The grown colonies were then identified using the BD Phoenix™ Automated Microbiology System. The identification results confirmed A. baumannii in both right and left BAL specimens. After receiving treatment based on susceptibility testing with trimethoprim-sulfamethoxazole at a dose of 960 mg twice daily for 5 days and undergoing a second wedge resection, the patient’s condition improved.
Figure 2. Acinetobacter baumannii colonies from the right BAL specimen on (a) Blood Agar, (b) Chocolate Agar, and (c) MacConkey Agar
Spontaneous pneumothorax (SP) is a condition in which air accumulates within the pleural cavity.3 SP can be classified as PSP, which occurs without underlying lung disease, or SSP, which is associated with pre-existing lung conditions, including bacterial infections.4 In this case, the patient experienced two episodes of SP, most likely caused by a lung infection associated with A. baumannii. This bacterial infection is an opportunistic pathogen in hospital environments and is often linked to nosocomial pneumonia, which can progress to serious complications, including necrotizing pneumonia and pneumothorax.1,5
A. baumannii infection in the lungs can lead to various complications, including recurrent pneumothorax, as observed in this case. A. baumannii can cause necrotizing pneumonia, which is characterized by severe inflammation and alveolar destruction. Patients with necrotizing pneumonia may experience rapid clinical deterioration, as reported by Chatha et al.6 The component responsible for epithelial cell adhesion and invasion is the outer membrane protein A (OmpA) of A. baumannii.7-9 This protein binds to the host cell surface, localizes to the mitochondria and nucleus, and induces cell death.10 A. baumannii can also cause alveolar rupture, allowing air to enter the pleural cavity, leading to pneumothorax.5 A. baumannii produces protease and phospholipase enzymes that degrade the structural components of host cells, leading to tissue damage and cavitation.11 Prolonged infection can result in the development of pulmonary bullae or cavitation due to extensive tissue destruction. These bullae may rupture spontaneously,12 causing recurrent pneumothorax, as observed in this case. Chronic inflammation from repeated infections can also weaken the lung tissue, making it more fragile and prone to rupture.
Several factors can increase the likelihood of recurrent spontaneous pneumothorax, including a prolonged infection with A. baumannii, as observed in this case, in which the patient’s lung tissue became vulnerable. The presence of bullae or cavities required the patient to undergo bullectomy wedge resection in both the initial and subsequent hospitalizations. Lung tissue damage caused by A. baumannii is particularly severe in patients with weakened immunity or in those who have undergone mechanical ventilation, which increases the risk of barotrauma.13 A history of chronic lung diseases, such as COPD or tuberculosis, can further exacerbate lung tissue vulnerability. Another contributing factor is antibiotic resistance, which leads to persistent inflammation and prolongs the lung tissue healing process owing to microorganisms that do not respond to standard antibiotic therapy. This is especially concerning as multidrug-resistant A. baumannii isolates are increasingly being found in clinical specimens. Patients with SP caused by A. baumannii infection have a variable prognosis, depending on the success of infection therapy, pneumothorax management, underlying lung conditions, and the extent of lung tissue damage caused by the microorganism. Recurrent SP, as observed in this patient, indicates significant lung damage, necessitating a treatment strategy that includes aggressive antibiotic therapy, strict infection control, and pulmonary intervention, if required. This case highlights the importance of early detection and optimal management of high-risk patients to prevent recurrence and further complications.
A. baumannii can cause lung tissue damage through inflammation, cavity formation, and necrosis, contributing to recurrent secondary spontaneous pneumothorax. Optimal management, including targeted antibiotic therapy and aggressive pneumothorax treatment, is essential to prevent recurrence and further complications.
ACKNOWLEDGMENTS
None.
CONFLICT OF INTEREST
The authors declare that there is no conflict of interest.
AUTHORS’ CONTRIBUTION
Both authors listed have made a substantial, direct, and intellectual contribution to the work, and approved it for publication.
FUNDING
None.
DATA AVAILABILITY
All datasets generated or analyzed during this study are included in the manuscript.
ETHICS STATEMENT
Not applicable.
INFORMED CONSENT
Written informed consent was obtained from the participant before enrolling in the study.
- Widysanto A, Liem M, Puspita KD, Pradhana CML. Management of necrotizing pneumonia with bronchopleural fistula caused by multidrug-resistant Acinetobacter baumannii. Respirol Case Rep. 2020;8(8):e00662.
Crossref - Herskovitz E, Nguyen N, Kaiser. Case of Necrotizing Pneumonia and Spontaneous Pneumothorax After Streptococcal and Stenotrophomonas Infection. Am J Respir Crit Care Med. 2024;(209:A3609).
https://doi.org/10.1164/ajrccm-conference.2024.209.1_MeetingAbstracts.A3609 - Sebayang ANO. Spontaneosus Pneumothorax. SCRIPTA SCORE Scientific Medical Journal. 2022;4(1):92-96.
Crossref - Costumbrado J, Ghassemzadeh S. Spontaneous Pneumothorax. Encyclopedia of Respiratory Medicine, Second Edition. 2023;4:463-473.
Crossref - Ghewade B, Abrahm E, Chaudhari S, Agrawal B. Pneumothorax in a case of community-acquired pneumonia due to Acinetobacter. The Journal of Association of Chest Physicians. 2017;5(2):83.
Crossref - Chatha N, Fortin D, Bosma KJ. Management of Necrotizing Pneumonia and Pulmonary Gangrene: A Case Series and Review of the Literature. Can Respir J. 2014;21(4):239-245.
Crossref - Yao Y, Chen Q, Zhou H. Virulence Factors and Pathogenicity Mechanisms of Acinetobacter baumannii in Respiratory Infectious Diseases. Antibiotics. 2023;12(12):1749.
Crossref - Zhang W, Zhou H, Jiang Y, et al. Acinetobacter baumannii Outer Membrane Protein A Induces Pulmonary Epithelial Barrier Dysfunction and Bacterial Translocation Through The TLR2/IQGAP1 Axis. Front Immunol. 2022;13:927955.
Crossref - Putri NL, Koendhori EB, Susilo I, Tambunan BA. The effect of low-electrical voltage as a method to eradicate Acinetobacter baumannii bacteria. 2023. Accessed February 10, 2025.
- Choi CH, Lee JS, Lee YC, Park TI, Lee JC. Acinetobacter baumannii invades epithelial cells and outer membrane protein A mediates interactions with epithelial cells. BMC Microbiol. 2008;8(1):1-11.
Crossref - Antunes LCS, Imperi F, Carattoli A, Visca P. Deciphering the Multifactorial Nature of Acinetobacter baumannii Pathogenicity. PLoS One. 2011;6(8):e22674.
Crossref - Gilday C, Odunayo A, Hespel AM. Spontaneous Pneumothorax: Pathophysiology, Clinical Presentation and Diagnosis. Top Companion Anim Med. 2021;45:100563.
Crossref - Ishaq MS, Arabi EY. The prevalence of pneumothorax in human immunodeficiency virus patients. A single center study. Saudi Med J. 2024;45(4):442-445.
Crossref
© The Author(s) 2025. Open Access. This article is distributed under the terms of the Creative Commons Attribution 4.0 International License which permits unrestricted use, sharing, distribution, and reproduction in any medium, provided you give appropriate credit to the original author(s) and the source, provide a link to the Creative Commons license, and indicate if changes were made.